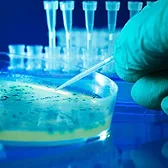

White Papers
Never miss the latest news and trends driving the food safety industry
Newsletters | Website | eMagazine
JOIN TODAY!Copyright ©2026. All Rights Reserved BNP Media, Inc. and BNP Media II, LLC.
Design, CMS, Hosting & Web Development :: ePublishing